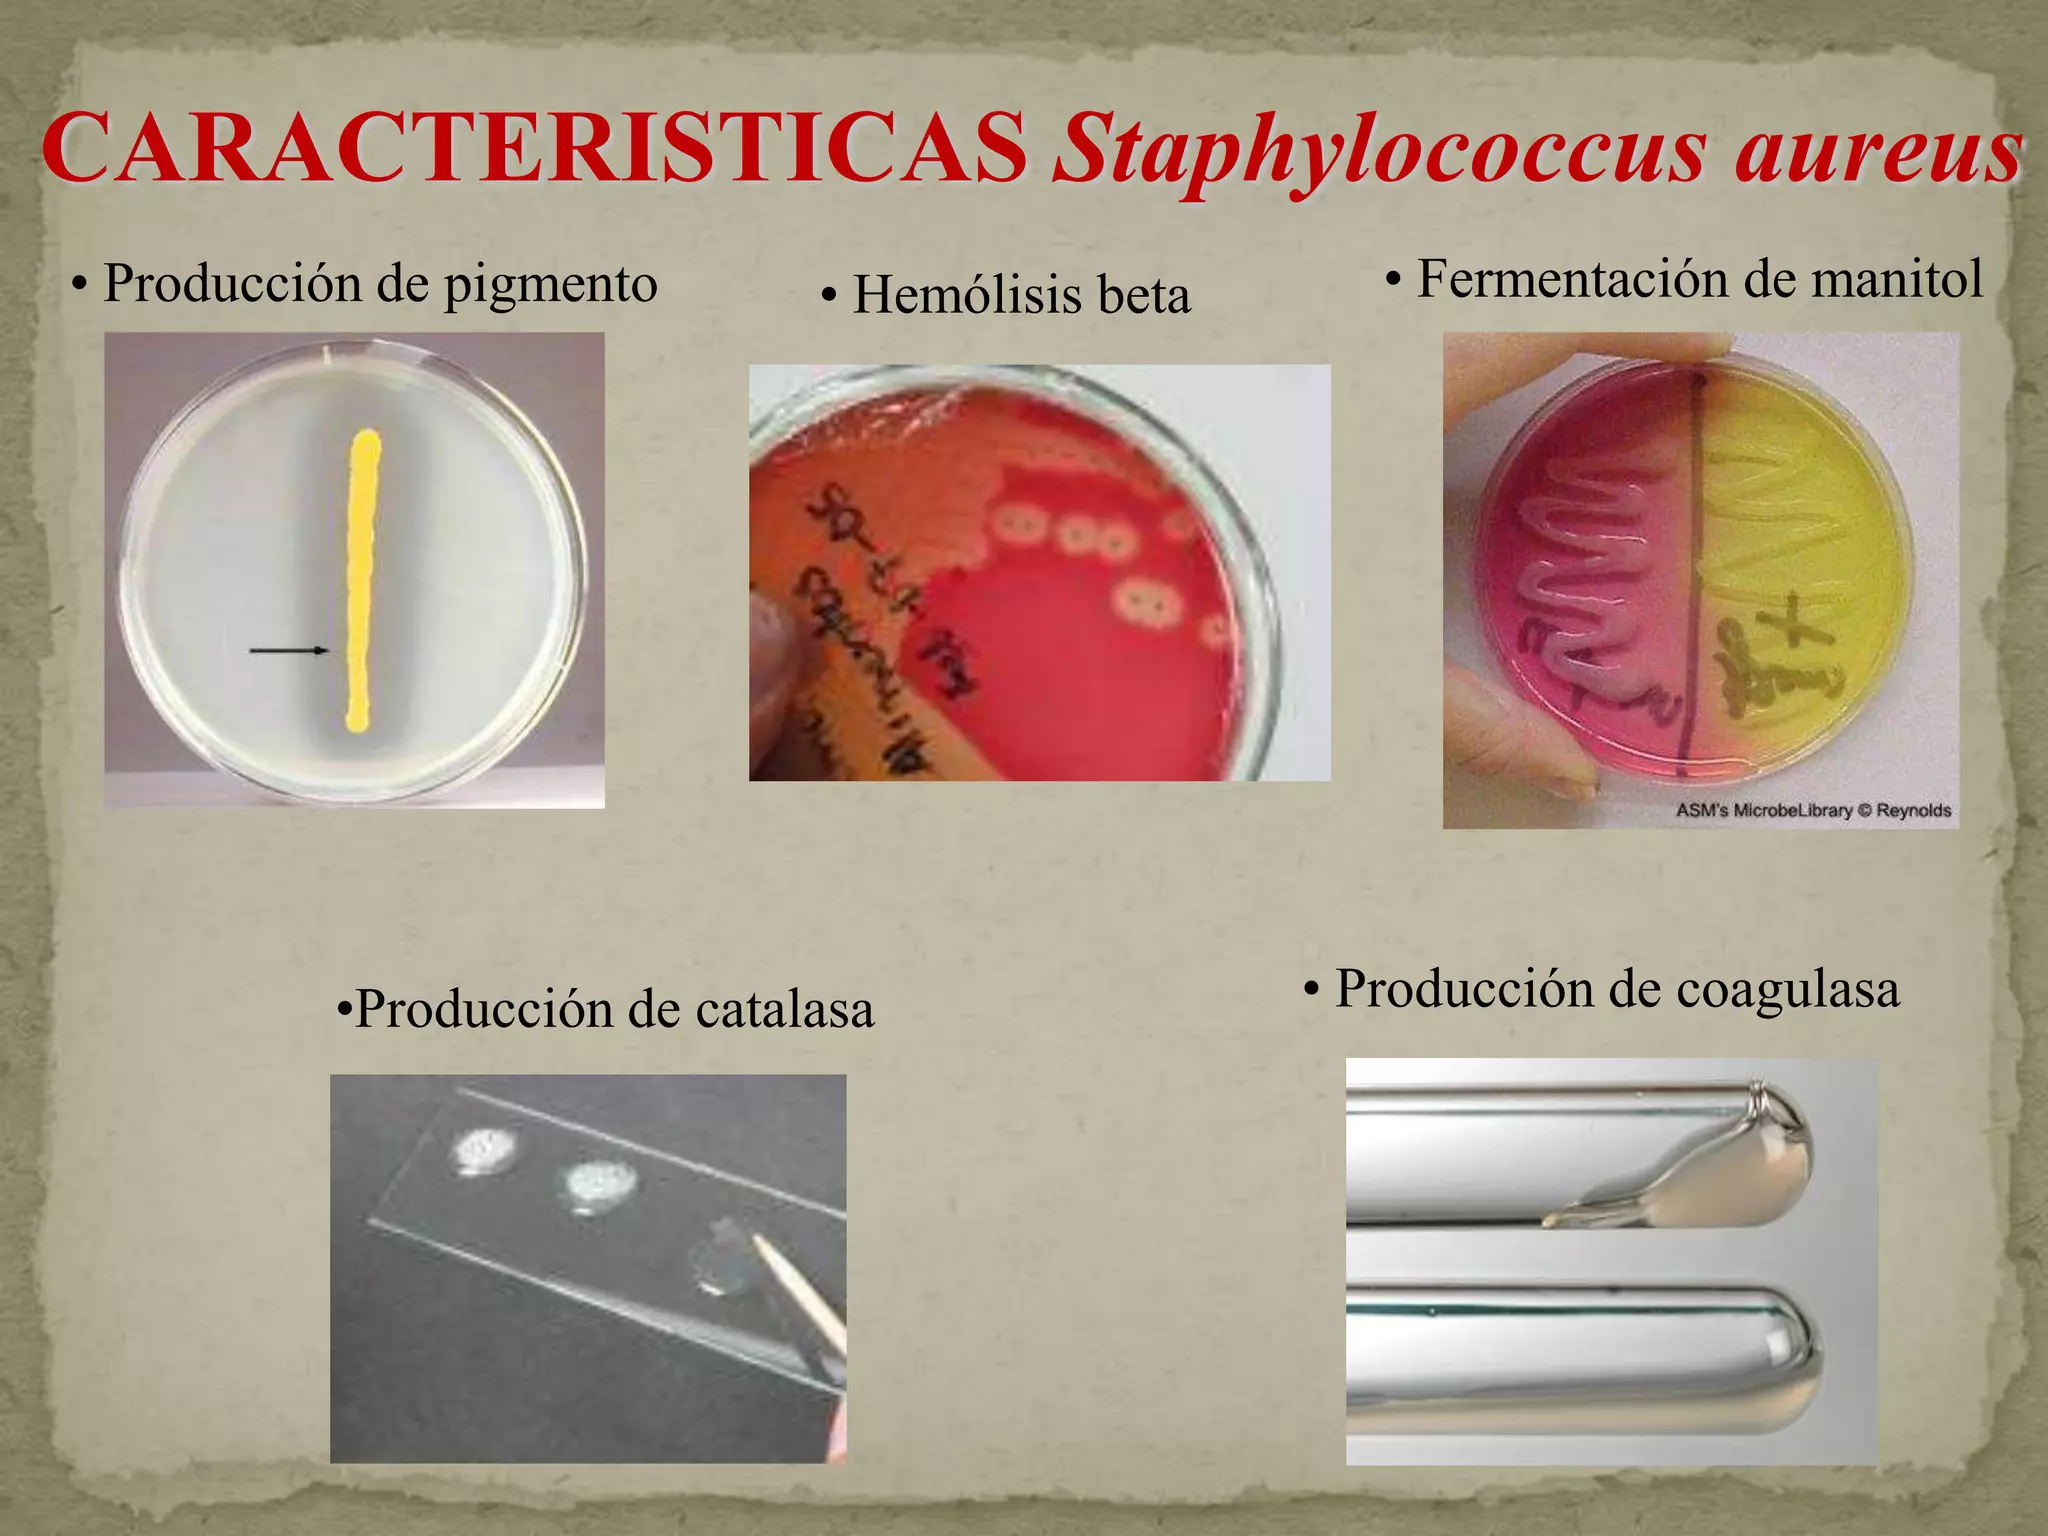
CARACTERISTICAS Staphylococcus aureus
• Producción de pigmento      • Hemólisis beta      • Fermentación de manitol




          •Producción de catalasa                • Producción de coagulasa
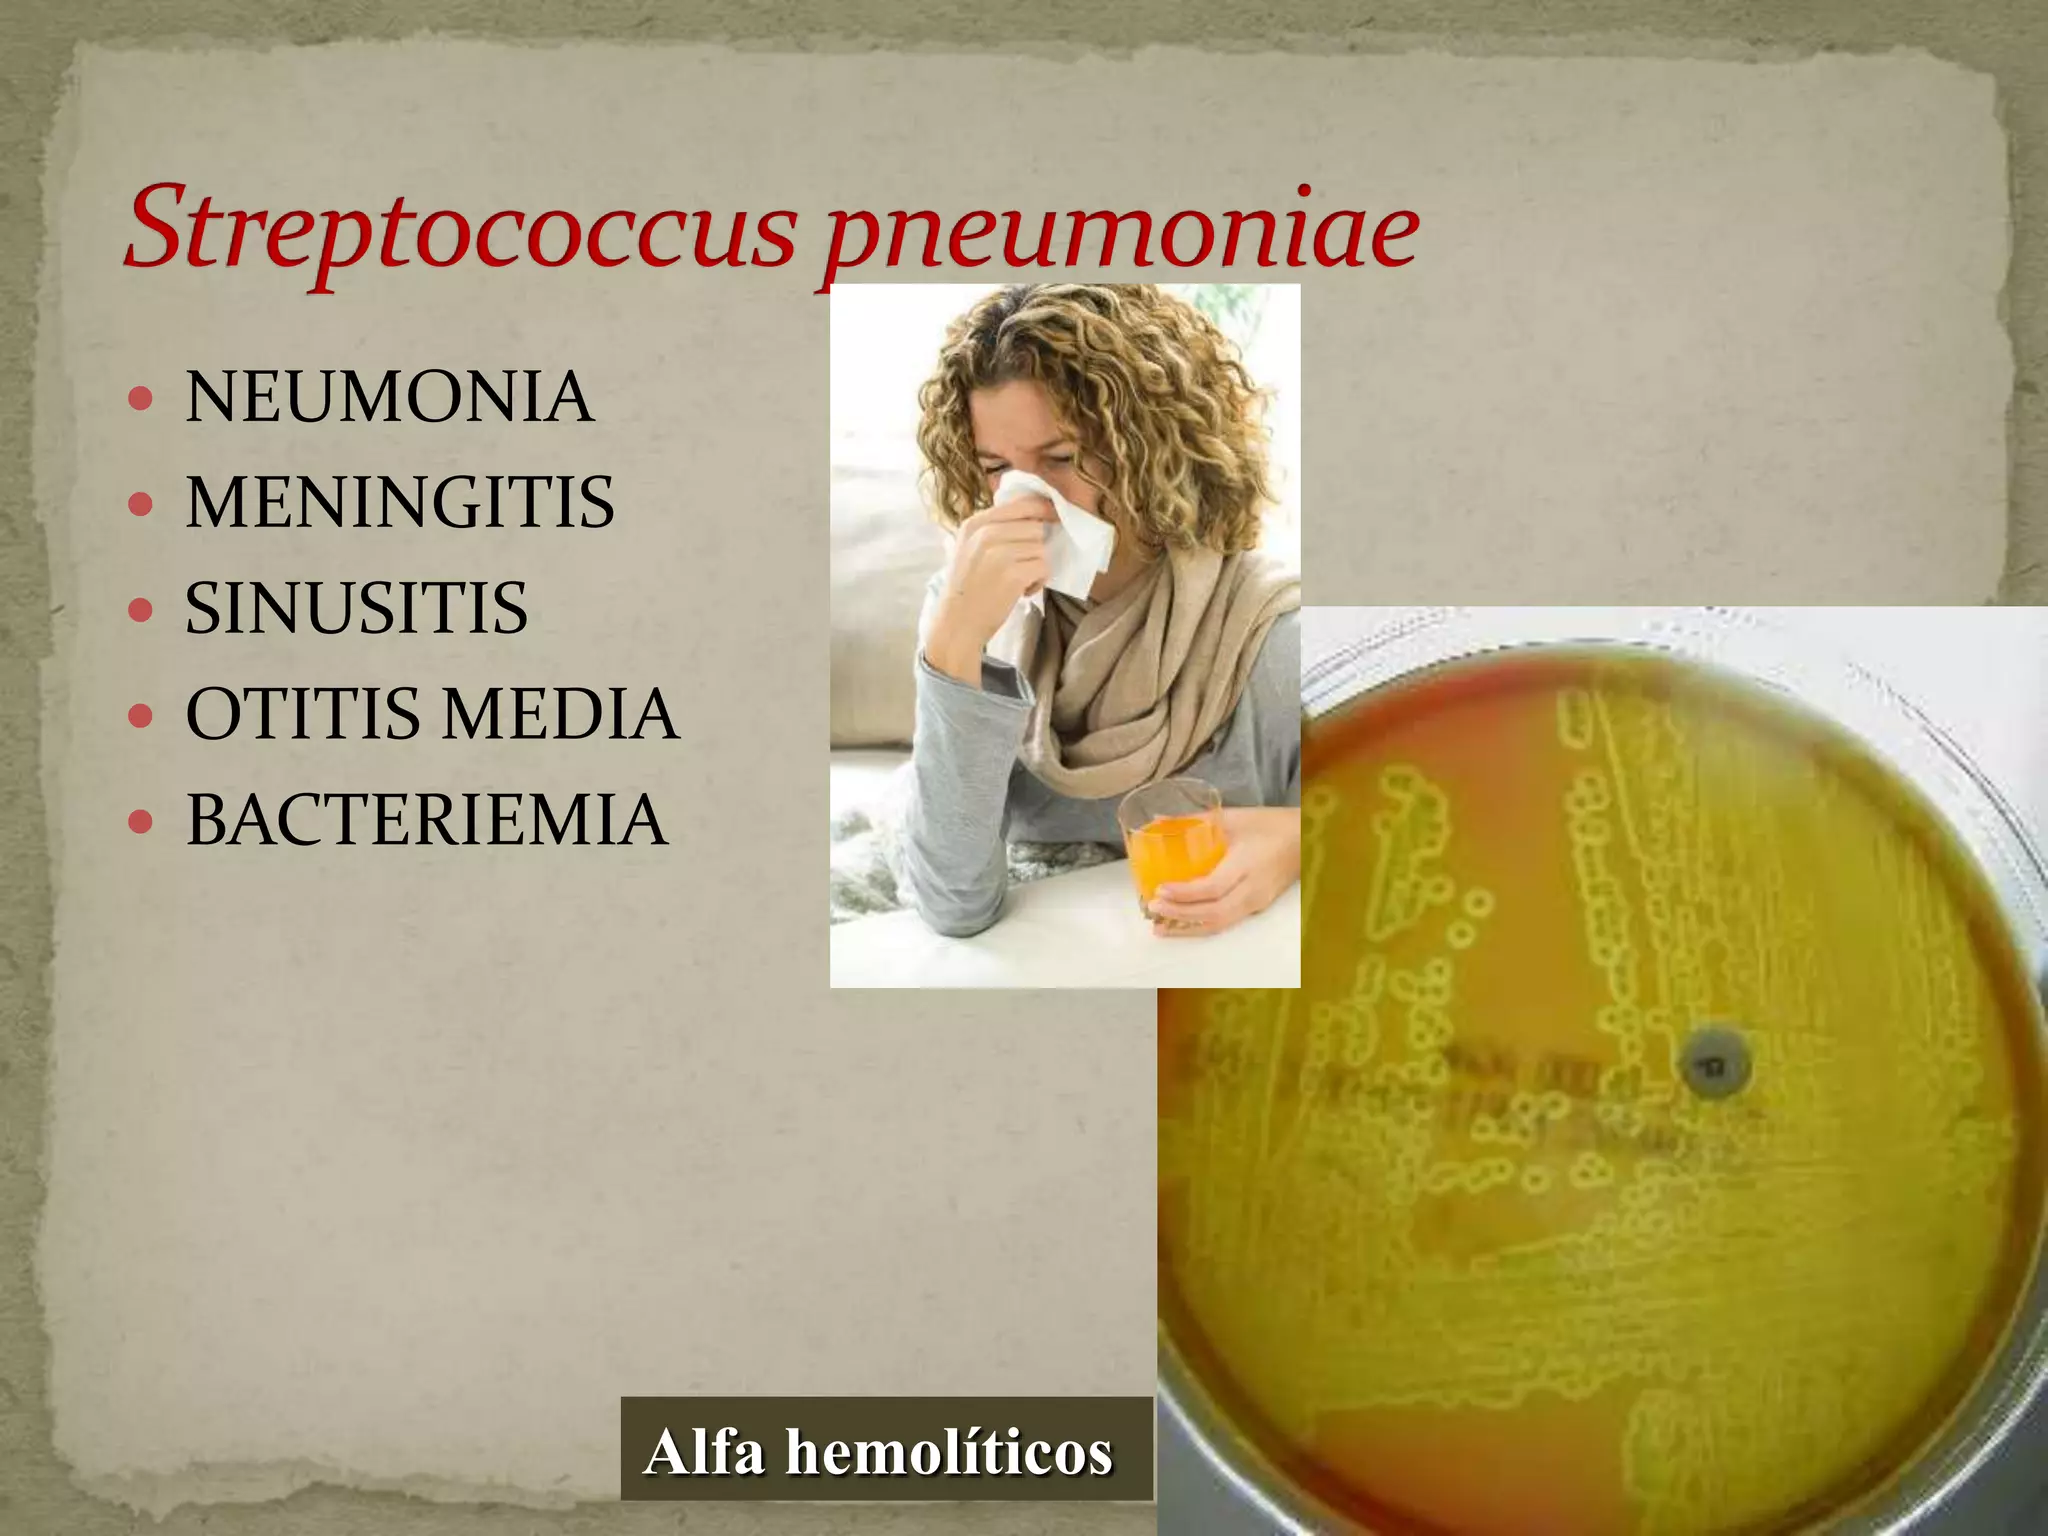
 NEUMONIA
 MENINGITIS
 SINUSITIS
 OTITIS MEDIA
 BACTERIEMIA




               Alfa hemolíticos

Este documento resume las características de los estafilococos y estreptococos. Describe las especies más importantes clínicamente como S. aureus, S. epidermidis y S. pyogenes. Explica sus factores de virulencia, patologías causadas y tratamiento. También clasifica los estafilococos y estreptococos según sus propiedades bioquímicas y antigénicas.